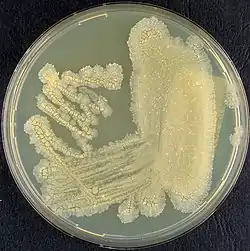

Tsukamurella pulmonis
Tsukamurella pulmonis es una bacteria grampositiva del género Tsukamurella. Fue descrita en el año 1996. Su etimología hace referencia a pulmón.[1] Es aerobia. En medio Löwenstein-Jensen y agar BHI forma colonias color cremoso, rugosas. Temperatura de crecimiento entre 24-37 °C, pero no a 45 °C. Catalasa positiva. Resistente a estreptomicina, isoniacida, etambutol, rifampicina, capreomicina y cicloserina. Inicialmente se aisló del esputo de una paciente con tuberculosis en Alemania.
| Tsukamurella pulmonis | ||
|---|---|---|
![]() Tsukamurella pulmonis | ||
| Taxonomía | ||
| Dominio: | Bacteria | |
| Filo: | Actinomycetota | |
| Clase: | Actinomycetes | |
| Orden: | Mycobacteriales | |
| Familia: | Tsukamurellaceae | |
| Género: | Tsukamurella | |
| Especie: |
Tsukamurella pulmonis Yassin et al. 1996 | |
Clínica
Tras su descripción, se ha aislado de varios orígenes humanos, desde muestras de conjuntivitis[2][3] y queratitis[4][5][6], hasta en sangre de bacteriemia por catéter,[7][8][9][10][11] esputos,[12][13] casos de neumonía,[14] incluso en un caso de bacteriemia y endocarditis.[15]
Hábitat
Por otro lado, se ha encontrado esta especie en aguas residuales[16] y en una pitón.[17] Los últimos estudios sobre taxonomía indican que la especie Tsukamurella spongiae, aislada en el año 2007 en una esponja marina,[18] es sinónimo de T. pulmonis.[19]
Referencias
- Yassin, A. F.; Rainey, F. A.; Brzezinka, H.; Burghardt, J.; Rifai, M.; Seifert, P.; Feldmann, K.; Schaal, K. P. (1996-04). «Tsukamurella pulmonis sp. nov». International Journal of Systematic Bacteriology 46 (2): 429-436. ISSN 0020-7713. PMID 8934902. doi:10.1099/00207713-46-2-429. Consultado el 13 de agosto de 2022.
- Woo, Patrick C. Y.; Ngan, Antonio H. Y.; Lau, Susanna K. P.; Yuen, Kwok-Yung (2003-07). «Tsukamurella conjunctivitis: a novel clinical syndrome». Journal of Clinical Microbiology 41 (7): 3368-3371. ISSN 0095-1137. PMC 165315. PMID 12843095. doi:10.1128/JCM.41.7.3368-3371.2003. Consultado el 13 de agosto de 2022.
- Almeida, David R.P.; Miller, Darlene; Alfonso, Eduardo C. (2010-06). «Tsukamurella: an emerging opportunistic ocular pathogen». Canadian Journal of Ophthalmology 45 (3): 290-293. ISSN 0008-4182. doi:10.3129/i09-252. Consultado el 13 de agosto de 2022.
- Leung, Kai Ching Peter; Au, Sunny Chi Lik; Ko, Tak Chuen Simon (2019-10). «Ophthalmic Manifestation of Tsukamurella Species: A Case Series and First Report of Ocular Implant Infection After Enucleation». Cornea 38 (10): 1328-1331. ISSN 1536-4798. PMID 31246677. doi:10.1097/ICO.0000000000001997. Consultado el 13 de agosto de 2022.
- Woo, Patrick C. Y.; Fong, Angie H. C.; Ngan, Antonio H. Y.; Tam, Dorothy M. W.; Teng, Jade L. L.; Lau, Susanna K. P.; Yuen, Kwok-Yung (2009-06). «First report of Tsukamurella keratitis: association between T. tyrosinosolvens and T. pulmonis and ophthalmologic infections». Journal of Clinical Microbiology 47 (6): 1953-1956. ISSN 1098-660X. PMC 2691093. PMID 19369436. doi:10.1128/JCM.00424-09. Consultado el 13 de agosto de 2022.
- Park, Benjamin Jinsung; Goosey, John D.; Belloso, Marcel (2021-10). «Tsukamurella keratitis: the first case in the United States». Canadian Journal of Ophthalmology. Journal Canadien D'ophtalmologie 56 (5): e153-e155. ISSN 1715-3360. PMID 33839066. doi:10.1016/j.jcjo.2021.03.005. Consultado el 13 de agosto de 2022.
- Schwartz, M. A.; Tabet, S. R.; Collier, A. C.; Wallis, C. K.; Carlson, L. C.; Nguyen, T. T.; Kattar, M. M.; Coyle, M. B. (1 de octubre de 2002). «Central venous catheter-related bacteremia due to Tsukamurella species in the immunocompromised host: a case series and review of the literature». Clinical Infectious Diseases: An Official Publication of the Infectious Diseases Society of America 35 (7): e72-77. ISSN 1537-6591. PMID 12228839. doi:10.1086/342561. Consultado el 13 de agosto de 2022.
- Leroy, A. G.; Persyn, E.; Guillouzouic, A.; Ruffier d'Epenoux, L.; Launay, E.; Takoudju, E.-M.; Juvin, M.-E.; Chantreau, F. et al. (2020-07). «Catheter-related bloodstream infection due to Tsukamurella pulmonis identified by MALDI-TOF spectrometry, 16S rRNA gene sequencing, and secA1 gene sequencing in an immunocompromised child: a case report and literature review». Diagnostic Microbiology and Infectious Disease 97 (3): 115052. ISSN 1879-0070. PMID 32312485. doi:10.1016/j.diagmicrobio.2020.115052. Consultado el 13 de agosto de 2022.
- Maertens, J.; Wattiau, P.; Verhaegen, J.; Boogaerts, M.; Verbist, L.; Wauters, G. (1998-01). «Catheter-related bacteremia due to Tsukamurella pulmonis». Clinical Microbiology and Infection: The Official Publication of the European Society of Clinical Microbiology and Infectious Diseases 4 (1): 51-53. ISSN 1469-0691. PMID 11864235. doi:10.1111/j.1469-0691.1998.tb00336.x. Consultado el 13 de agosto de 2022.
- Suzuki, Jun; Sasahara, Teppei; Toshima, Masaki; Morisawa, Yuji (11 de octubre de 2017). «Peripherally inserted central catheter-related bloodstream infection due to Tsukamurella pulmonis: a case report and literature review». BMC infectious diseases 17 (1): 677. ISSN 1471-2334. PMC 5637316. PMID 29020942. doi:10.1186/s12879-017-2796-8. Consultado el 13 de agosto de 2022.
- Ochi, Kiyoaki; Mukai, Tomoyuki; Ota, Shigeru; Hiraiwa, Chihiro; Ikeda, Masahiko; Ikeda, Airi; Oda, Takashi; Yamamoto, Youichiro et al. (2021-09). «Tsukamurella pulmonis central venous catheter infection mimicking proteinase 3-antineutrophil cytoplasmic antibody (PR3-ANCA)-associated vasculitis». Immunological Medicine 44 (3): 211-215. ISSN 2578-5826. PMID 32649848. doi:10.1080/25785826.2020.1791403. Consultado el 13 de agosto de 2022.
- Liu, Chia-Ying; Lai, Chih-Cheng; Lee, Meng-Rui; Lee, Yi-Chieh; Huang, Yu-Tsung; Liao, Chun-Hsing; Hsueh, Po-Ren (2011-12). «Clinical characteristics of infections caused by Tsukamurella spp. and antimicrobial susceptibilities of the isolates». International Journal of Antimicrobial Agents 38 (6): 534-537. ISSN 1872-7913. PMID 22014886. doi:10.1016/j.ijantimicag.2011.07.018. Consultado el 13 de agosto de 2022.
- Perez, Vinicio A. de Jesus; Swigris, Jeffrey; Ruoss, Stephen J. (14 de junio de 2008). «Coexistence of primary adenocarcinoma of the lung and Tsukamurella infection: a case report and review of the literature». Journal of Medical Case Reports 2: 207. ISSN 1752-1947. PMC 2442117. PMID 18554413. doi:10.1186/1752-1947-2-207. Consultado el 13 de agosto de 2022.
- Maalouf, Roger; Mierau, Susanna B.; Moore, Thomas A.; Kaul, Anand (20 de enero de 2009). «First case report of community-acquired pneumonia due to Tsukamurella pulmonis». Annals of Internal Medicine 150 (2): 147-148. ISSN 1539-3704. PMID 19153422. doi:10.7326/0003-4819-150-2-200901200-00022. Consultado el 13 de agosto de 2022.
- Malik, Zain; Shah, Punit J.; Tariq, Farheen (2020-10). «First report of Tsukamurella endocarditis in an immunocompromised patient receiving chemotherapy». European Journal of Clinical Microbiology & Infectious Diseases: Official Publication of the European Society of Clinical Microbiology 39 (10): 1989-1991. ISSN 1435-4373. PMID 32361958. doi:10.1007/s10096-020-03917-5. Consultado el 13 de agosto de 2022.
- Soler, Albert; García-Hernández, Jorge; Zornoza, Andrés; Alonso, José Luis (2018-01). «Diversity of culturable nocardioform actinomycetes from wastewater treatment plants in Spain and their role in the biodegradability of aromatic compounds». Environmental Technology 39 (2): 172-181. ISSN 1479-487X. PMID 28264640. doi:10.1080/09593330.2017.1296897. Consultado el 13 de agosto de 2022.
- Maeda, Y.; Stanley, T.; Stirling, J.; Griffiths, M.; Calvert, A.; Stuart Elborn, J.; Cherie Millar, B.; Goldsmith, C. E. et al. (2010-12). «No evidence of transmission of bacteria between reptiles and a CF patient--a case report of a young adult CF patient and reptiles». Zoonoses and Public Health 57 (7-8): e47-53. ISSN 1863-2378. PMID 19968847. doi:10.1111/j.1863-2378.2009.01293.x. Consultado el 13 de agosto de 2022.
- Olson, Julie B.; Harmody, Dedra K.; Bej, Asim K.; McCarthy, Peter J. (2007-07). «Tsukamurella spongiae sp. nov., a novel actinomycete isolated from a deep-water marine sponge». International Journal of Systematic and Evolutionary Microbiology 57 (Pt 7): 1478-1481. ISSN 1466-5026. PMID 17625179. doi:10.1099/ijs.0.64837-0. Consultado el 13 de agosto de 2022.
- Teng, Jade L. L.; Tang, Ying; Huang, Yi; Guo, Feng-Biao; Wei, Wen; Chen, Jonathan H. K.; Wong, Samson S. Y.; Lau, Susanna K. P. et al. (2016). «Phylogenomic Analyses and Reclassification of Species within the Genus Tsukamurella: Insights to Species Definition in the Post-genomic Era». Frontiers in Microbiology 7: 1137. ISSN 1664-302X. PMC 4955295. PMID 27493643. doi:10.3389/fmicb.2016.01137. Consultado el 13 de agosto de 2022.